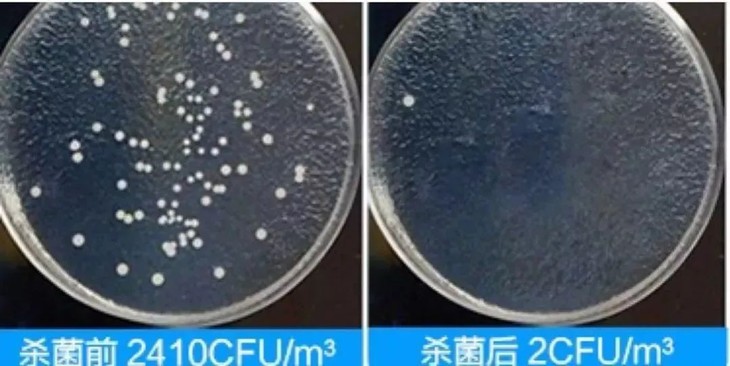

🐮 厨房浴室重油污克星🚫【DIGE涤戈多功能家用清洁剂】 ⤴️1瓶顶多瓶,全新升级多种表面活性剂,有效抑均99.99% ✔️持久去污多效合一,配方温和不伤手
| 运费: | 免运费 |
| 库存: | 100 件 |
商品详情



一转眼又到了年底,感觉年才刚过完 怎么又要过年了?年底一到 意味着新一届的“年底大扫除”即将开始。 正所谓,年底扫除,扫去“霉运” 家里越干净,运气也会越好

可每到大扫除的时候,就令人头疼!十分头疼! 像厨房、浴室这种重灾区 简直是所有人的噩梦!费力还不一定搞得干净!

特别是油烟机、灶台这样的地方 长时间使用下来,全是黑兮兮,滑腻腻的油污...

每次擦洗油烟机的时候不仅脖子酸,手也酸。 要命的是,擦了老半天还没有擦干净!

买了一堆清洁剂 不同区域还得更换对应的清洁剂 真的是“差生工具多”

可是,依然没有解决问题: ❌一些气味大超级刺鼻 ❌一些需要稀释,浸泡预涂,很浪费时间 一句话总结就是用了也是白用。

还有一些容易腐蚀锅具; 那些化学添加剂不仅会残留在锅碗中 还一直残留在手上,又干又涩还发痒!

正当我在愁着年底大扫除这件事情 同事安利一款不费力轻松搞定全屋清洁的好东西

这款不呛鼻子的多功能家用清洁剂 它就是神一般的存在! 温和配方,强力去污,方便又省力 家里有一瓶它就够了。 涤戈-多功能家用清洁剂

涤戈可不是普通的小品牌 在广东有着自己的研发实验基地 光产品配方就有300多种 每一款产品都严格按照国家标准制造! 是最新研发的多功能家用清洁剂,配方温和不伤手

还能深层渗透,有效杀灭物体表面的常见细菌 清洁消毒合二为一,能让陈年老油污老污渍都消失 同时不伤材质,让我忍不住想要马上安利给大家!

1瓶顶多瓶,能清洁玻璃、瓷砖、油烟机、 灶台、风扇、车座、鞋子、马桶、锅具…… 几乎家里但凡有脏了的地方,它都能解决!

有了它家里不用备各种瓶瓶罐罐,一瓶搞定所有 从厨房到浴室、从黑锅底到老瓷砖、不锈钢 从玩具到茶桌、书桌,轻轻松松擦干净!

成分温和,不挑材质。 无论是鞋子、沙发、坐垫 只要是你能想到的,它都可以清洁。

不管是多么顽固的污渍 在它面前都得乖乖服软。

蕞重要的是,它有着一股淡淡的柠檬味。 好闻不刺鼻,这已经秒杀一众清洁剂了!

以往大扫除都是三四天起步 现在有了它,分分钟搞定,实在太节省时间了! 看着焕然一新的房间,真的很有成就感!



厨房绝对是大扫除的重点目标 而这款清洁剂就是“厨房重油污克星” 品牌方撂下一句狠话: 不管多重的油污,不用拆洗就能清洁到位!

咱们来直观感受一下 普通清洁剂和涤戈多功能清洁剂两者的区别: ❌普通清洁剂无法分解 ✅涤戈多功能清洁剂轻松溶解油垢

它的表面活性剂洗涤配方,喷在油污处 静置两分钟左右,油污在泡泡包围下自动溶解了

每天都在做饭的灶台,黏糊油腻、厚厚一层油垢 普通洗洁精和根本处理不干净,钢丝球也没辙

用它对着油污处喷一喷 再擦一擦,瞬间干净到反光!

我最讨厌洗油烟机,真的很难洗! 哪怕是用刷子、钢丝球大力摩擦 污渍还是牢牢趴在上面

而这款清洁剂超牛的,直接渗透污渍内部 “乳化拔除”,可以简单理解为: “智取”打入敌人内部瓦解恶势力,既省时又省力

不管你家的油烟机有多少“不堪入目” 用它喷一喷,等待一会后擦干净,亮的跟新的一样

经常使用的微波炉,电烤箱上附着的油污脏东西 用它乳化油污后再用清水一擦 再也不用担心油污滴到饭菜里了!

厨房里的水池,平时洗碗、洗菜之后 水垢、油渍残留在上面看起来十分老旧 用了它之后,水池立马重现光泽

就连水槽上粘着的油污也能清洗干净 洗菜洗碗时也看着舒心!

如果非要找一个词来形容它 那只有4个字:强得可怕! 去重油污真的太猛了!


既然是多功能清洁剂,肯定是不能局限于厨房 为了试探一下它到底能有多去污 我们直接来到了一个老式小区的卫生间 做了一个清洁实验,摇一摇清洗剂之后 将泡沫喷在卫生间墙面、地面、马桶等地方

静置20秒以后,我们都不用刷也不用擦 只需要简单用喷头冲走泡沫,卫生间墙面、马桶 等地方的污迹会被泡沫分解自动剥落下来

平时刷一次马桶要耗费20多分钟 不仅要闻着马桶的臭味,还要耗费好大的力气 用这款清洁剂,不用刷 只需30秒就能彻底洗干净马桶,省时又省力~

像平常洗脸用的洗手盆也是很会藏污渍水垢 边边角角、水龙头把手,直接拿起清洁剂 喷一喷,抹一抹,冲一冲,一下子亮晶晶~

再来到一面油渍满满的墙面进行试验: 只需要一喷,再用抹布一擦 墙面瞬间焕然一新,完全就像新的一样。

同事说到车里进行试验一下: 用黑色笔画上去,手擦不掉 用清洁剂轻轻一喷,用布一抹,干干净净

接着拿有色的大头笔,在座椅上随便写了几个字: 清洁剂喷一喷,绵密的泡沫瞬间溶解 轻轻一擦便恢复了原状

汽车方向盘、座椅、内饰,甚至是车身和轮毂等~ 都可以用清洁剂来清洗,轻松做到洗车不用一滴水~

脏兮兮的小白鞋也能搞定 不用费力刷鞋,每天拥有干净体面

各种电器的充电线、排插等 清洁后也摇身一变,崭新如初!

像浴室墙角旮旯边缘发黄发黑的污渍: 喷一喷,等个2分钟,直接用水冲,瞬间干净!

玻璃门上大片的水垢,只需要一喷一抹 就能还你一个干净卫生的浴室空间!

说它是多功能,它就肯定不会让你失望。 凡是你能想到的,想清洁的 用它,一喷,一抹,一冲,干干净净!


这么强的去污能力,想必不安全吧? 这你就把心放到肚子里去! 它真正做到了强去污+温和不伤手+不伤材质!

它之所以能有这么强的清洁效果 得益于它的配方足够强大。 采用了多重去污因子 高效表面活性剂+电解离子水+含氧溶剂+润湿铺展剂。 能快速渗透、分解污渍,同时 做到了免洗免晒,快干无痕!

具有非常好的清洁力和抑菌力 可以有效的将油脂进行乳化分离 对油污和蛋白质都有很强的去除效果。

同时采用的是温和植物配方 对器具座椅等任何材质、以及人没有任何的伤害 使用时不用戴手套,也不会对皮肤造成伤害

我们还专门用酸碱度测试纸测试: 可以看到涤戈酸碱度为弱碱中性 PH值6~7,温和不刺激。

大家都知道,但凡有污渍的地方 绝对是少不了细菌: 卫生间、车内、手提的皮包等都有大量细菌。

这款清洗剂除了清洁能力外 还采用独有的抑jun除jun配方: 对于常见的金黄色葡萄球菌等都可以有效清除

经过了专业的检测显示 它的抑jun率达到99.99%! 是真正意义上优质清洁剂 要知道很多清洁剂还没有检测报告呢!

为了证明它真的有抑菌效果 我们特地找了浴室的洗脸池作为试验: 未使用清洁剂时细菌量达到600多 使用完20分钟之后,细菌的存活率几乎为零 抑jun效果非常好!
不伤手+能去污+能抑jun,真的是一瓶顶多瓶。 有它就能轻松搞定全屋清洁,是不是很省心?


它是旋转开关喷头设计,要旋转一下才能喷哦。

泡泡非常绵密,可以更快渗入油污内部 快速溶解油污,一喷一擦,干干净净。

使用之前可以用力摇一摇,这样泡泡会更绵密 像这个是轻轻摇晃,泡泡不多但清洁效果是一样的

想让哪里变干净就喷哪里! 它真的是众多清洁剂中的神!

某宝搜清洁剂,大多都是29.9元而且均为单一功能

这么一看涤戈这款多功能家用清洁剂性价比很高 39.9元直接可以拥有3瓶,你说这大便宜上哪找

500ml大容量,一瓶可以用很久了。 用途广泛,玻璃、油烟机、墙面、鞋子、窗帘等 各种生活用品都可以用它来清洁 容量大,用处还多,真的是爱了!

话不多说,这次只争取到500单! 保质期三年,大家赶紧给自己和父母备上几瓶吧~

- 懂货好单线报
- 你懂我,我懂货,爆品一起来团购
- 扫描二维码,访问我们的微信店铺